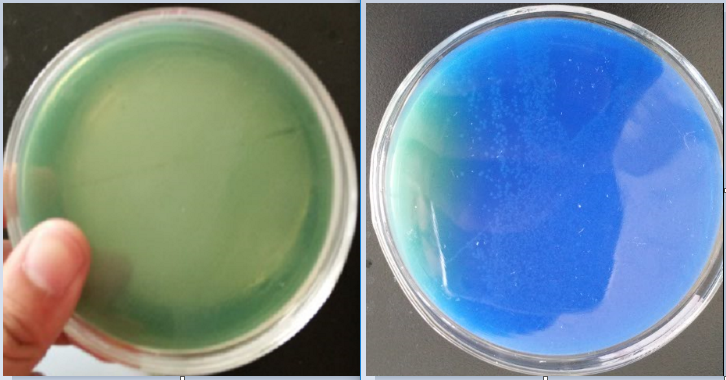
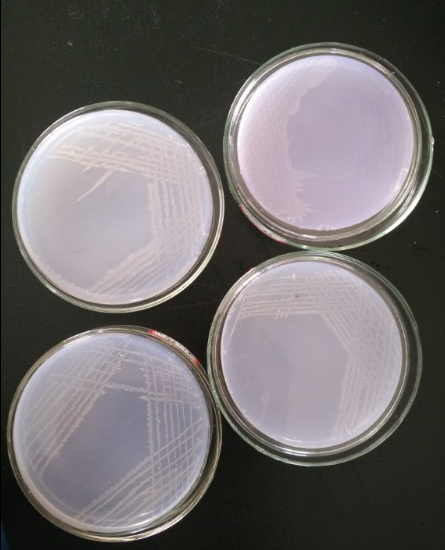
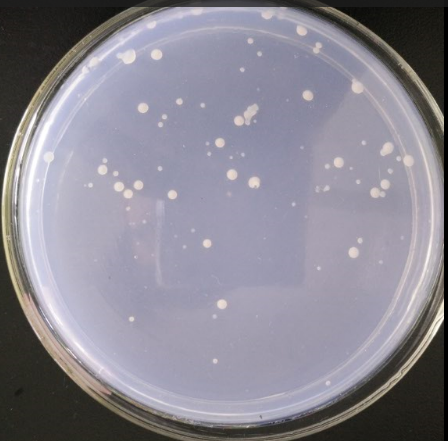

高温反硝化菌抑制油井中硫酸盐还原菌的应用研究毕业论文
2020-04-10 16:03:02
摘 要
硫化氢和硫酸盐还原菌是造成油田注水开发后期油井腐蚀的主要因素,针对这种现状,生物防腐研究和应用最为广泛的是硝酸盐基处理技术。该技术所运用的原理为,DNB在与SRB竞争生长环境空间与营养物质时,能够优先利用油田废水中的营养物质,减少了SRB可利用的营养物和生存空间,抑制其生长代谢。
本文从富集出的耐高温(65℃以上)反硝化菌中筛选出在模拟油井条件下能高效抑制SRB生长的菌株,对其进行条件优化,并对其应用研究,得出主要结论如下:
(1)本研究从油井废水原水中通过多次筛选、分离、纯化得到四株反硝化细菌菌株,其中菌株DNB-3的生长状况最好。将所选取的菌株DNB-3与NO3-设置对照试验,生长于油田废水原水中,其中加入了菌液与NO3-的一组S2-浓度下降了45%,效果最明显,验证了DNB对高温油井废水中SRB生长的抑制作用。
(2)本研究对所分离出的菌株DNB-3的生长条件进行了条件优化,经过实验得出:该菌生长周期为96h,最适pH=7.5, 最适温度65℃,最优氮源为硝酸钾,最优氮源浓度为75mg/L。
(3)本文对菌株DNB-3抑制油井废水中富含的SRB进行了实际应用研究。取菌株DNB-3于油田废水原水中进行实验,在65℃恒温摇床体系中生长两天后,S2-去除率为82%,总氮浓度减少率为19.6%,实验效果显著。
关键词:高温反硝化细菌;硫酸盐还原菌(SRB);油井废水;生物防治;
Abstract
Hydrogen sulfide and sulfate reducing bacteria are the main factors that cause oil well corrosion in the late development of oil field. In view of this situation, the most widely used research and application of biological anticorrosion is the nitrate base treatment technology. The principle of this technology is that, when DNB is competing with SRB to grow the environment space and nutrients, it can take advantage of the nutrients in the oilfield wastewater, reduce the available nutrients and living space, and inhibit the growth and metabolism of SRB.
In this paper, the strains of high temperature resistant (over 65) denitrifying bacteria which could inhibit the growth of SRB under simulated oil well conditions were selected and optimized. The primary conclusions were as follows:
(1) Four strains of denitrifying bacteria were isolated from the raw water of the oil well wastewater through many screening, separation and purification. The growth of DNB-3 bacteria was the best. The selected DNB-3 strain and NO3- were set in the control test, which grew in the raw water of the oilfield wastewater. The concentration of a group of S2- decreased by 45%, and the effect was the most obvious. The inhibition of DNB on the growth of SRB in the high temperature oil well wastewater was verified.
(2) The conditions of the growth of the isolated DNB-3 bacteria were optimized in this study. The single factor and orthogonal experiment showed that the growth cycle of the bacteria was 96h, the optimum growth conditions were as follows: pH was 7.5, the temperature was 65, the best nitrogen source was potassium nitrate and the concentration was 75mg/L.
(3) The practical application of strain DNB-3 to inhibit SRB in oil well wastewater is studied in this paper. The strain DNB-3 was tested in the raw water of oil field. After two days in the constant temperature rocking system at 65 ℃, the removal rate of S2- was 82% and the total nitrogen concentration decreased to 19.6%. The results of the experiment were remarkable.
Key words: high temperature denitrifying bacteria; sulfate reducing bacteria (SRB); oil well wastewater; biological control;
目 录
Abstract IV
第1章 绪论 1
1.1 油井废水的来源、危害及处理现状 1
1.1.1 油井废水的来源、危害 1
1.1.2 油井废水的处理现状。 1
1.2 硫化氢的危害 1
1.3 硫酸盐还原菌的研究进展 2
1.3.1 SRB的种类 2
1.3.2 SRB的生态条件 2
1.3.3 SRB的基本环境因子 2
1.3.4 SRB的防治方法 3
1.4 反硝化细菌的研究进展 3
1.4.1 DNB的种类 4
1.4.2 DNB的生理特性 4
1.4.3 DNB生长的环境条件 4
1.5 反硝化细菌DNB对硫酸盐还原菌SRB的抑制 4
1.6 本课题研究的目的及内容 5
1.6.1 研究课题的目的及意义 5
1.6.2 研究课题的主要内容 5
1.6.3 本研究的技术路线 6
第2章 反硝化细菌的筛分、纯化及其活性研究 7
2.1 实验材料与仪器 7
2.1.1 菌株来源 7
2.1.2 实验仪器及药品 7
2.1.3 培养基配方及实验试剂 8
2.2 检测方法 8
2.2.1 OD600的测量 8
2.2.2 脱氮率的计算 8
2.2.3 硫离子的测定 9
2.3 实验方法 9
2.3.1 反硝化细菌的筛选、分离和保存 9
2.3.2 标准曲线的绘制 10
2.3.3 菌株的生长曲线测定 12
2.3.4 验证DNB对SRB的抑制作用 12
2.4 结果与讨论 13
2.4.1 DNB菌株的筛选、分离与保存 13
2.4.2 菌株生长曲线的研究 14
2.4.3 DNB对SRB的生长抑制作用的验证 15
2.5 本章小结 18
第3章 反硝化细菌生长条件优化 19
3.1 实验方法 19
3.1.1 不同pH下的菌株生长条件优化 19
3.1.2 不同氮源的菌株生长条件优化 19
3.1.3 不同氮源浓度的菌株生长条件优化 19
3.2 结果与讨论 20
3.2.1 不同pH对菌株DNB-3抑制SRB能力的影响 20
3.3.2 不同氮源对菌株DNB-3抑制SRB能力的影响 20
3.3.3 同一氮源不同浓度对菌株DNB-3抑制SRB能力影响 21
3.3.4 最优培养条件下菌株DNB-3的生长情况 22
3.4 本章小结 22
第4章 反硝化细菌的实际应用研究 24
4.1 实验材料与方法 24
4.1.1 水样、菌株及培养基 24
4.1.2 实验仪器及药品 24
4.1.3 实验方法 24
4.2 结果与讨论 24
4.3 本章小结 26
第5章 结论与存在的问题 27
5.1 结论 27
5.2 存在的问题 27
致谢 29
参考文献 30
第1章 绪论
1.1 油井废水的来源、危害及处理现状
1.1.1 油井废水的来源、危害
随着社会经济的迅速发展,油田作为工业生产的必须物质基础,人们对于原油资源的需求量日益增加,同时在开采和加工原油过程中所产生油井废水的排放量也随之增加,对环境的污染与人类的健康造成很大的危害。如今我国很多采用注水开采的油田已属于高度含水的状态,这将对集输管线,回注水管线和原油污水处理系统造成十分严重的腐蚀与危害[1]。
注水开采过程中,水通过注水井进入油层,随后与原油混合经采油井返回地面。这些水在运输出口原油前需进行处理,将污水与原油分离,故被称为油田采出水 [2]。如今油田开采年代不断增加,采出水含水率已多数超过90% [3],含油污水对油田的危害越来越大。
石油生产过程中,集输系统由井口、计量间、接转站、联合站等部分构成,从而采出井下石油并使其成为满足标准的原油。而地层中的SRB就随采出的石油一起来到地面上,集输系统的油井废水条件适宜,SRB大量生长,将硫酸盐还原为H2S,产生大量的H2S腐蚀管道,使原油酸化,危害环境和人类健康[4]
1.1.2 油井废水的处理现状。
目前处理油井废水的方法可分为以下几类:
第一种为物理法,其主要任务是废水中矿物质和大部分固体悬浮物、油类等的去除,主要方法包括重力分离、过滤、离心分离、粗颗粒化、膜分离和蒸发等[5]。
第二种化学法则用于废水中一部分胶体和溶解性物质的处理,这些物质不能通过单独的物理或生物方法去除,尤其是油井污水中的乳化油,主要分为混凝沉淀、化学转化和中和法[6]。
第三种物理化学法应用最多的有气浮法和吸附法两种。
最后生物法利用的是微生物生化作用,将复杂的有机物分解为简单物质,使废水得到处理,由是否供应氧气区分好氧和厌氧生物处理[7]。生物法相对于物理法和化学法而言成本低,投资少,且效率高,无二次污染,现各国普遍使用[8]。
1.2 硫化氢的危害
H2S是一种具有刺激性的有毒臭味气体,对人体多方面损害较大,而且还污染环境,腐蚀设备[9]。
H2S气体可以对人体呼吸系统、循环系统和神经系统等造成不同程度的损伤。H2S由呼吸道进入人体后,反应生成硫化钠,阻碍了细胞呼吸作用而发生缺氧性中毒。当硫化氢的含量较高时,神经系统会由兴奋转为抑制继而呼吸麻痹,最终导致电击式中毒。H2S还刺激皮肤黏膜,损伤眼部及鼻子等处黏膜,引发炎症及视力下降。
H2S相对分子质量稍大于空气,对大气和水源影响较大。H2S在大气中被氧化为SO2,增加酸性气体的含量,造成局部地区的酸雨性气候,破坏周边地区的公共设施,对生态环境也有很大危害[10]。
在工业生产中,H2S易发生反应生成硫化物堵塞管道、污染滤料、腐蚀设备[11]。长时间在富含硫化氢的环境下,一些非金属类密封件如石棉绳、橡胶、浸油石墨等会失去弹性,导致密封不紧密,引起仪表爆裂、装置损坏等危害,硫化氢气体遇到火源甚至还会引发着火爆炸[12]。对于石油生产,H2S造成的主要影响有储层变酸、硫化物腐蚀、硫化铁地层堵塞、产量降低等。
1.3 硫酸盐还原菌的研究进展
1.3.1 SRB的种类
油井废水中的H2S主要就是由油田管道系统中的硫酸盐还原菌(sulfate reducing bacteria,简称SRB)所产生的。SRB是一类将硫酸盐或其他氧化态硫化物等硫源作为电子受体,异化环境中的碳源有机物的厌氧细菌。SRB可生长在海洋,水田,湖沼,河川底泥,海底泥,土壤,石油矿床和硫磺矿床中,它们具有多种形态及营养类型,最早于1895年由Beijerinck[13]发现,历史悠久。
Niddel和Pfenning在第一版伯捷系统细菌学手册第一卷第一次给出SRB属检查表,将其分为8个属。随着不断发现新的菌种, SRB已分为12个属,近40多个种[14]。最容易分离的是不产芽孢的嗜温革兰氏阴性菌株,低盐度条件下也有产芽孢的革兰氏阳性,另外还有革兰氏阴性嗜热真细菌和革兰氏阴性古细菌的记录。
1.3.2 SRB的生态条件
SRB主要以硫酸盐作为最终电子受体进行厌氧呼吸作用,研究发现,SRB不仅可以利用硫酸盐生长,还能以其他约100种底物作电子供体。
1.3.3 SRB的基本环境因子
SRB可生存的温度范围是-5℃—75℃,且能够迅速适应新的温度条件,最佳生长温度为37.5℃;可生存的pH范围是5—9.5,在7.0—7.8的pH下生长最好;在含盐量很高的一些环境,如盐水湖中仍能找到SRB的存在。最容易分离到的嗜盐菌为轻度嗜盐菌,最佳含盐率为1%—4%,能够分离到的中度嗜盐菌较少,其最适宜的盐度为10%左右[15];其生长要求的Eh低于-150mV[16]。
1.3.4 SRB的防治方法
目前防治SRB采用的主要有下列几种方法:
- 物理方法
SRB的物理防治方法可分为电离射线和超声波杀菌、环境因素控制、防腐材料应用等[17]。SRB生长所必要的营养物质中,除了一般细菌要求的Na 、K 、Mg2 、Ca2 、SO42-、Cl-、CO32-、HP2O4-、NH4 外,还对铁离子的存在有一定要求,而Mn2 、Cu2 和Zn2 等却会抑制其生长。通过降低硫源碳源浓度,适当调节温度pH条件可防治SRB的腐蚀。
- 化学方法
化学方法是最简单有效的控制SRB的方法,在油田和冷却水系统中被广泛使用,其主要原理是通过投加抗生素杀死SRB、或投加抑制剂来抑制SRB的活性与代谢[18]。但使用单一药剂一段时间后,细菌的抗药性会显著提升。因此,开发新型、高效、环保、廉价的杀菌剂是近年来微生物腐蚀研究和控制的一个有前景的研究方向。
- 阴极保护方法
阴极保护的基本措施是与涂层结合使用。阴极保护方法以金属表面为阴极,引起碱性环境,控制细菌的活性[19]。处理SRB时,防护对象的阴极极化电位保持-0.95V(相对于Cu-CuSO4电极)以下。在-0.95~-1.1VCu-CuSO4电位范围内,SRB活性强反应生成FeS层,可保护一段时间。当电位负于-1.1VCu-CuSO4时,阴极保护稳定形成。
- SRB的生物防治
SRB生物防治原理为:一方面,选用生活条件与SRB类似的细菌,与SRB在同一环境中竞争生存空间与营养物质,抑制SRB的生长,减少H2S的生成;另一机制是,选用一些产生类似抗生素的细菌,杀灭SRB或处理环境中的H2S。所以,生物防治主要是利用微生物之间的共生、竞争以及拮抗作用来防治SRB的腐蚀[20]。
1.4 反硝化细菌的研究进展
1.4.1 DNB的种类
DNB是对硝酸盐或亚硝酸盐通过氧化还原作用而产生N2O和N2的细菌。反硝化细菌在分类学上的定义尚未规范,目前归类于原核生物的一些属,大部分在细菌界,少数在古生菌界[21]。
1.4.2 DNB的生理特性
生物脱氮以利用硝酸盐为底物进行的呼吸作用为基础,DNB作为硝酸盐呼吸的载体,硝酸盐呼吸是DNB的标志性特征。反硝化过程由多个过程组成(NO3-→NO2-→NO→N2O→N2),本质为硝酸盐的生物还原过程,产生NO,N2O和N2等气态产物。而NO毒性很强,几乎没有以其作为最终产物的细菌。反硝化的生物化学反应过程如图1.1所示
图1.1反硝化的生化反应过程
1.4.3 DNB生长的环境条件
大部分DNB是兼性厌氧细菌,以氧或硝酸盐作为电子受体,进行有氧呼吸,缺氧时硝酸盐作为代替进行厌氧呼吸。虽然在此过程中硝酸根的作用与氧一样,从呼吸链中接收电子,但硝酸根作为电子受体时基质释放的能量减少。若硝酸盐被硫酸盐取代,基质释放的能量也会减少[22]。
以上是毕业论文大纲或资料介绍,该课题完整毕业论文、开题报告、任务书、程序设计、图纸设计等资料请添加微信获取,微信号:bysjorg。
相关图片展示:

您可能感兴趣的文章
- 用于甲醇制烯烃反应的SAPO-34/ZSM-5复合催化剂的原位水热结晶合成外文翻译资料
- 硫化氢在活体的化学发光探针成像外文翻译资料
- 全色发射型ESIPT荧光团对某些酸及其共轭碱负离子识别的颜色变化外文翻译资料
- 一种用于成像神经元细胞和海马组织中NMDA受体附近内源性ONOO-的双光子荧光探针外文翻译资料
- 表面功能化的Ui0-66/pebax基超薄复合中控纤维气体分离膜外文翻译资料
- 金属有机框架中的可逆调节对本二酚/醌反应:固态固定化分子开关外文翻译资料
- 二维MXene薄片的尺寸相关物理和电化学性质外文翻译资料
- 将制甲烷的Co催化剂转化为产甲醇的In@Co催化剂外文翻译资料
- MXene分子筛膜用于高效气体分离外文翻译资料
- 模板导向合成具有排列通道和增强药物有效荷载的立方环糊精聚合物外文翻译资料


